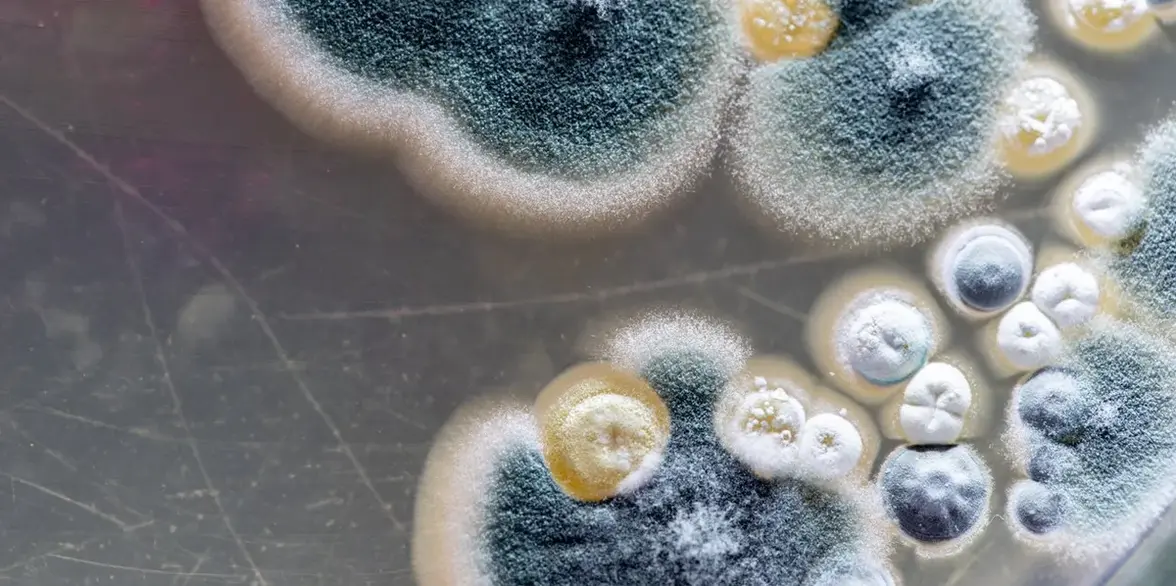
Изменение климата может сделать грибки более опасными

Повышение температуры может вызвать у грибков мутации, которые приводят к более агрессивному росту или лекарственной резистентности.
Ученые давно опасаются, что повышение температуры на Земле может сделать грибки более опасными для человека. И вот недавно китайские исследователи наткнулись на доказательства, подтверждающие это предположение. В ходе изучения грибковых инфекций в китайских больницах исследователи обнаружили грибок, который ранее не встречался у людей и заразил двух пациентов. Патоген уже был устойчив к двум наиболее распространенным противогрибковым препаратам, а когда его подвергли воздействию высоких температур, у него быстро развилась резистентность к третьему препарату, что сделало его практически не поддающимся лечению существующими лекарствами.
Полученный результат "подтверждает идею о том, что глобальное потепление может способствовать эволюции этого грибкового патогена или других новых грибковых патогенов", - утверждает Линьци Ван, микробиолог из Института микробиологии Китайской академии наук и соавтор исследования, посвященного этим грибкам, опубликованного недавно в журнале Nature Microbiology. "Это поистине неожиданное открытие, которое сулит недоброе будущее", - говорит Дэвид Деннинг, исследователь инфекционных заболеваний из Манчестерского университета, не принимавший участия в исследовании.
Грибки вызывают меньше заболеваний человека, чем бактерии или вирусы, по двум причинам: иммунная система человека очень хорошо справляется с ними, и они обычно плохо растут при высокой температуре тела млекопитающих. Однако за последние несколько десятилетий грибковые инфекции стали более распространенными, поскольку все больше людей живут с ослабленной иммунной системой в результате эпидемии ВИЧ и приема лекарственных препаратов, подавляющих иммунную систему. В последние годы у людей появилось несколько совершенно новых грибковых инфекций, комментирует Асия Гуса, микробиолог из Университета Дьюка, и, что вызывает беспокойство, некоторые из них уже были резистентными к антимикотикам, говорит она. "Это довольно поразительно и немного пугающе". Один из важнейших вопросов заключается в том, может ли повышение температуры, вызванное изменением климата, помочь грибкам, живущим в окружающей среде, адаптироваться к теплу человеческого тела и выработать устойчивость к лекарствам. Новое исследование показывает, что в некоторых случаях это так и происходит.
В рамках программы по поиску грибков, вызывающих тяжелые заболевания у людей, исследователи отобрали образцы у пациентов 96 больниц в Китае в период с 2009 по 2019 год. Среди тысяч собранных штаммов грибков один никогда ранее не был задокументирован как инфицирующий человека: Rhodosporidiobolus fluvialis. Он был выделен из крови двух не связанных между собой пациентов, проходивших лечение в отделениях интенсивной терапии в связи с тяжелыми основными заболеваниями: 61-летнего мужчины из Нанкина, умершего в 2013 году, и 85-летней женщины из Тяньцзиня, умершей в 2016 году. Патоген был устойчив к флуконазолу и каспофунгину - двум основным препаратам, используемым для лечения опасных для жизни грибковых инфекций у людей.
Чтобы доказать, что грибок действительно может инфицировать млекопитающих, исследователи ввели его мышам с ослабленной иммунной системой. Мыши действительно заболели, но произошло и нечто неожиданное: некоторые грибки быстро мутировали в более агрессивную форму. Когда исследователи проверили, почему так происходит, они обнаружили, что клетки, культивируемые при 37°C, накапливают мутации в 21 раз быстрее, чем клетки, культивируемые при 25°C. А когда исследователи культивировали R. fluvialis при 37°C и подвергали его воздействию другого распространенного противогрибкового препарата - амфотерицина B, то у него гораздо быстрее развивалась резистентность к этому лекарству. "Новый патоген, устойчивый к противогрибковым препаратам и способный становиться все более устойчивым к ним при более высоких температурах, просто поразителен, - говорит Деннинг.
Поскольку грибки процветают в холоде, переход к температуре человеческого тела может привести к стрессовой реакции, которая повышает вероятность их мутаций, объясняет Артуро Касадевалл, микробиолог из Школы общественного здоровья имени Джона Хопкинса Блумберга. "Возможно, нам придется начать рассматривать более высокие температуры, такие как у млекопитающих, как мутагенные для грибков", - говорит он. Это может иметь серьезные последствия, поскольку температура на Земле становится все выше. "Если грибки реагируют на температуру млекопитающих геномными изменениями, то можно предположить, что аналогичные события могут происходить и в очень теплые дни", - говорит Касадевалл.
"Если это так, то изменение климата не только повысит риск адаптации грибков к более высоким температурам, что облегчит им заражение людей, но и заставит их стать более агрессивными и менее чувствительными к лекарствам".
По словам Гусы, об этом еще рано говорить, но она прогнозирует, что больше исследователей будут пытаться выращивать грибки при более высоких температурах. Маловероятно, что все они начнут мутировать сильнее, говорит она, "но если это будет происходить достаточно часто и мы начнем видеть, как эта модель повторяется, это вызовет беспокойство".
Что касается R. fluvialis, то Мэтью Фишер, эпидемиолог по грибковым заболеваниям из Имперского колледжа Лондона, пока не считает его новой угрозой. Похожие виды были обнаружены в глубинах Балтийского моря, в почве Антарктиды и в Мертвом море, поэтому люди редко вступают с ними в контакт, говорит он. "Мое первое ощущение - это то, что в Китае есть неисследованные среды, в которых обитают эти грибки, и что этим двум пациентам не повезло, и они подверглись их воздействию". Хотя биология грибка интересна, это исследование "отражает скорее хорошую клиническую микробиологию в малоизученной части мира, чем зарождающееся грибковое заболевание в стиле сериала "Последние из нас", - говорит Фишер, имея в виду драматический сериал, в котором грибковая пандемия приводит к краху цивилизации.
"Надеюсь, я прав!" - добавляет он.